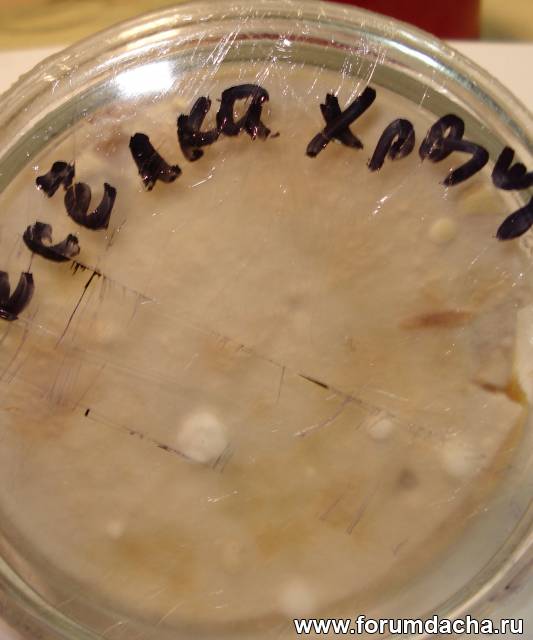

|

| Автор |
Сообщение |
bbcom |
|
|
Зарегистрирован: 11.02.2013
Сообщения: 221
Откуда: МО
|

|
31-03-2014, 15:27 |
 Заголовок сообщения: |
Я и присылал.  И если что, он у меня по-прежнему есть, могу продублировать.
|
|
Александр Дворянинов |
|
|
Зарегистрирован: 30.05.2012
Сообщения: 482
|

|
31-03-2014, 22:33 |
 Заголовок сообщения: |
| Romul писал(а): |
| Александр, а мутинус не восстановили? Вроде bbcom хотел прислать? |
Восстановил, но растёт тоже медленно.
|
|
Александр Дворянинов |
|
|
Зарегистрирован: 30.05.2012
Сообщения: 482
|

|
01-04-2014, 15:58 |
 Заголовок сообщения: |
| bbcom писал(а): |
Я и присылал. И если что, он у меня по-прежнему есть, могу продублировать. И если что, он у меня по-прежнему есть, могу продублировать. |
Весёлку обыкновенную и Мтинус нужно искать быстро растущие штаммы, к пимеру Мутинус собачий, явный ксилотроф.
Александр Иванович обещал прислать, при оказии. bbcom как у Вас успехи по введению в культуру быстро растущего штамма Весёлки обыкновенной?
|
|
bbcom |
|
|
Зарегистрирован: 11.02.2013
Сообщения: 221
Откуда: МО
|

|
02-04-2014, 17:47 |
 Заголовок сообщения: |
Чистую культуру, пока, к сожалению, получить так и не удалось.  То ли руки кривые, то ли это какой-то странный союз Веселки и быстрорастущей плесени, которая во всех случаях (а я провел более сотни опытов) за несколько дней забивает всю ЧП после чего культуру Веселки от-туда выдернуть не представляется возможным. Сейчас я экспериментирую с селективными средами. Здесь есть кое-какое движение, но опять же, положительного результата я пока не достиг. Так же хочу сказать, что судя по развитию этого штамма на средах типа "сосновые опилки", быстрого роста я не наблюдаю, обе Веселки растут приблизительно одинаково.
Кстати, если хотите, могу выслать Вам для экспериментов тяжи, которые передал мне в декабре Romul. Я отрезАл от них по кусочку, но там еще что-то осталось. Всхожесть проверял буквально неделю назад.
|
|
Александр Кузнецов |
|
|
Зарегистрирован: 23.10.2009
Сообщения: 6776
Откуда: Алтайский край, р.ц.Алтайское
|

|
02-04-2014, 20:39 |
 Заголовок сообщения: |
| Александр Дворянинов писал(а): |
| Мтинус нужно искать быстро растущие штаммы, к пимеру Мутинус собачий, явный ксилотроф. Александр Иванович обещал прислать, при оказии. |
Сезон начался. Буду наблюдать. и постараюсь выслать мицелий на опилочном субстрате, как только подберу подходящий. 
|
|
Александр Дворянинов |
|
|
Зарегистрирован: 30.05.2012
Сообщения: 482
|

|
02-04-2014, 20:53 |
 Заголовок сообщения: |
| Александр Кузнецов писал(а): |
| Александр Дворянинов писал(а): |
| Мтинус нужно искать быстро растущие штаммы, к пимеру Мутинус собачий, явный ксилотроф. Александр Иванович обещал прислать, при оказии. |
Сезон начался. Буду наблюдать. и постараюсь выслать мицелий на опилочном субстрате, как только подберу подходящий.  |
Благодарю Александр Иванович!
|
|
Александр Дворянинов |
|
|
Зарегистрирован: 30.05.2012
Сообщения: 482
|

|
02-04-2014, 21:04 |
 Заголовок сообщения: |
| bbcom писал(а): |
Чистую культуру, пока, к сожалению, получить так и не удалось.  То ли руки кривые, то ли это какой-то странный союз Веселки и быстрорастущей плесени, которая во всех случаях (а я провел более сотни опытов) за несколько дней забивает всю ЧП после чего культуру Веселки от-туда выдернуть не представляется возможным. Сейчас я экспериментирую с селективными средами. Здесь есть кое-какое движение, но опять же, положительного результата я пока не достиг. Так же хочу сказать, что судя по развитию этого штамма на средах типа "сосновые опилки", быстрого роста я не наблюдаю, обе Веселки растут приблизительно одинаково. То ли руки кривые, то ли это какой-то странный союз Веселки и быстрорастущей плесени, которая во всех случаях (а я провел более сотни опытов) за несколько дней забивает всю ЧП после чего культуру Веселки от-туда выдернуть не представляется возможным. Сейчас я экспериментирую с селективными средами. Здесь есть кое-какое движение, но опять же, положительного результата я пока не достиг. Так же хочу сказать, что судя по развитию этого штамма на средах типа "сосновые опилки", быстрого роста я не наблюдаю, обе Веселки растут приблизительно одинаково.
Кстати, если хотите, могу выслать Вам для экспериментов тяжи, которые передал мне в декабре Romul. Я отрезАл от них по кусочку, но там еще что-то осталось. Всхожесть проверял буквально неделю назад. |
Действительно создаётся впечатление что у ней союз с посторонними контаминантами, просто ещё не все методы опробованы. Я тоже бился со многими культурами, но результата всё таки удалось добиться, bbcom если не трудно оправьте мне культуру Весёлки, я тоже опробую. Селективные среды это конечно вещь, только в том случае, когда в неё сеешь чистую культуру! Взамен естественно любую культуру из каталога!
|
|
Александр Кузнецов |
|
|
Зарегистрирован: 23.10.2009
Сообщения: 6776
Откуда: Алтайский край, р.ц.Алтайское
|

|
04-04-2014, 17:36 |
 Заголовок сообщения: |
Интересные наблюдения, однако!?
|
|
Romul |
|
|
Зарегистрирован: 19.04.2012
Сообщения: 318
Откуда: Москва
|

|
06-04-2014, 18:54 |
 Заголовок сообщения: |
| bbcom писал(а): |
| то ли это какой-то странный союз Веселки и быстрорастущей плесени |
Тоже думал об этом. Потому, что во всех емкостях с тяжами веселки была эта маленькая бархатистая плесень. Даже, если в какой-нибудь емкости прорастал другой конкурент, этот был обязательно.
|
|
iwur |
|
|
Зарегистрирован: 09.01.2012
Сообщения: 168
Откуда: Ульяновская обл Павловский район с.Ст. Пичеур
|

|
08-04-2014, 10:26 |
 Заголовок сообщения: |
Я исхожу из спроса, да каракатица есть в банке культур. Есть Весёлка обыкновенная, Весёлка Адриана, Сетконоска, Весёлка хрящеватая, Решоточник.
Весёлку Андриана заказал . когда можно заказать остальные?
|
|
Александр Дворянинов |
|
|
Зарегистрирован: 30.05.2012
Сообщения: 482
|

|
09-04-2014, 08:29 |
 Заголовок сообщения: |
| iwur писал(а): |
Я исхожу из спроса, да каракатица есть в банке культур. Есть Весёлка обыкновенная, Весёлка Адриана, Сетконоска, Весёлка хрящеватая, Решоточник.
Весёлку Андриана заказал . когда можно заказать остальные? |
Всё появится в Банке культур, мимо ничего не пройдёт.
|
|
Romul |
|
|
Зарегистрирован: 19.04.2012
Сообщения: 318
Откуда: Москва
|

|
09-04-2014, 14:50 |
 Заголовок сообщения: |
Вольвариелла на вьетнамском рынке:

купил несколько штук:

выстрелила:


Шимиджи серый:

шимиджи белый:

|
|
mafanya11 |
|
|
Зарегистрирован: 21.04.2014
Сообщения: 3
|

|
21-04-2014, 11:30 |
 Заголовок сообщения: |
iwur
Доброго дня. Насколько возможно приобретение мицелия Веселки обыкновенной у Вас? Живу в Томске. Спасибо.
|
|
iwur |
|
|
Зарегистрирован: 09.01.2012
Сообщения: 168
Откуда: Ульяновская обл Павловский район с.Ст. Пичеур
|

|
21-04-2014, 21:12 |
 Заголовок сообщения: |
мицелий веселки обыкновенной можно приобрести у Александра Дворянинова . желательно сделать предзаказ . а когда он будет рассылать можно узнать на первой странице в пятом посту данной темы.
|
|
iwur |
|
|
Зарегистрирован: 09.01.2012
Сообщения: 168
Откуда: Ульяновская обл Павловский район с.Ст. Пичеур
|

|
21-04-2014, 21:19 |
 Заголовок сообщения: |
вот что у него на сегодня есть в продаже .
1 пакет = 800 грамм
Стоимость одного пакета = 200 руб...
В наличии мицелий:
Опёнок настоящий (Armillaria mellea) растёт на изолированных субстратах (блоках)
Шимиджи коричневый(hypsizygus marmoreus)
Шиитаке 370 (lentinula edodes)
Энтолома недоразвитая(Entoloma lividoalbum)
Трамета разноцветная (trametes versicolor)
Вешенка 1500 (pleurotus ostreatus)
Мейтаке (grifola frondosa) московский регион
Весёлка Адриана (phallus hadriani)
Шимиджи белый (hypsizygus tessulatus)
|
|
mafanya11 |
|
|
Зарегистрирован: 21.04.2014
Сообщения: 3
|

|
22-04-2014, 10:49 |
 Заголовок сообщения: |
я все понял, к Александру обращался, говорит, нету, насчет предзаказа ничего не говорил, я к нему еще обращусь. По ходу общения я понял, что у Вас тоже что-то есть, ну вот и написал.
|
|
Александр Дворянинов |
|
|
Зарегистрирован: 30.05.2012
Сообщения: 482
|

|
05-06-2014, 21:32 |
 Заголовок сообщения: |
Удалось получить яйца на чашке петри Весёлки хрящеватой, это говорит о том что она будет плодоносить и на изолированных субстратах, как и Весёлка Адриана. 
|
|
Александр Кузнецов |
|
|
Зарегистрирован: 23.10.2009
Сообщения: 6776
Откуда: Алтайский край, р.ц.Алтайское
|

|
06-06-2014, 20:10 |
 Заголовок сообщения: |
Тоже интересный факт.. пробуйте на субстратах.
|
|
Александр Дворянинов |
|
|
Зарегистрирован: 30.05.2012
Сообщения: 482
|

|
06-06-2014, 20:22 |
 Заголовок сообщения: |
Для того чтобы опробовать на субстратах должно пройти определённое
время. На самом деле не всё так просто.
|
|
Александр Кузнецов |
|
|
Зарегистрирован: 23.10.2009
Сообщения: 6776
Откуда: Алтайский край, р.ц.Алтайское
|

|
06-06-2014, 20:30 |
 Заголовок сообщения: |
Да уж, я это очень даже осознаю, после нескольких лет наблюдений!
|
|
|
|
|
|
|
 |
|
Вы не можете начинать темы
Вы не можете отвечать на сообщения
Вы не можете редактировать свои сообщения
Вы не можете удалять свои сообщения
Вы не можете голосовать в опросах
Вы не можете вкладывать файлы
Вы можете скачивать файлы
|
|
|
 И если что, он у меня по-прежнему есть, могу продублировать.
И если что, он у меня по-прежнему есть, могу продублировать.
 И если что, он у меня по-прежнему есть, могу продублировать.
И если что, он у меня по-прежнему есть, могу продублировать.



 То ли руки кривые, то ли это какой-то странный союз Веселки и быстрорастущей плесени, которая во всех случаях (а я провел более сотни опытов) за несколько дней забивает всю ЧП после чего культуру Веселки от-туда выдернуть не представляется возможным. Сейчас я экспериментирую с селективными средами. Здесь есть кое-какое движение, но опять же, положительного результата я пока не достиг. Так же хочу сказать, что судя по развитию этого штамма на средах типа "сосновые опилки", быстрого роста я не наблюдаю, обе Веселки растут приблизительно одинаково.
То ли руки кривые, то ли это какой-то странный союз Веселки и быстрорастущей плесени, которая во всех случаях (а я провел более сотни опытов) за несколько дней забивает всю ЧП после чего культуру Веселки от-туда выдернуть не представляется возможным. Сейчас я экспериментирую с селективными средами. Здесь есть кое-какое движение, но опять же, положительного результата я пока не достиг. Так же хочу сказать, что судя по развитию этого штамма на средах типа "сосновые опилки", быстрого роста я не наблюдаю, обе Веселки растут приблизительно одинаково.